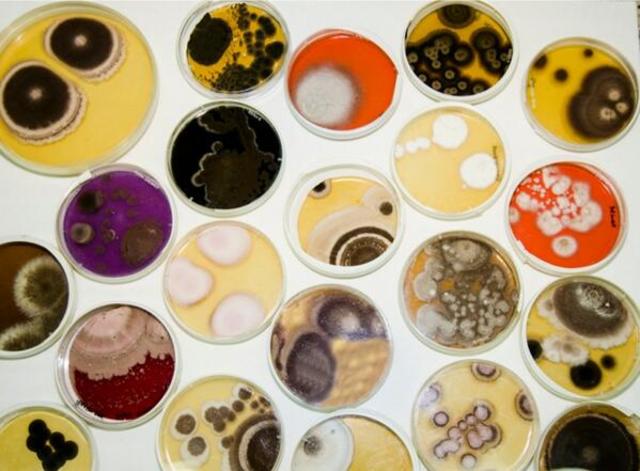
Micología
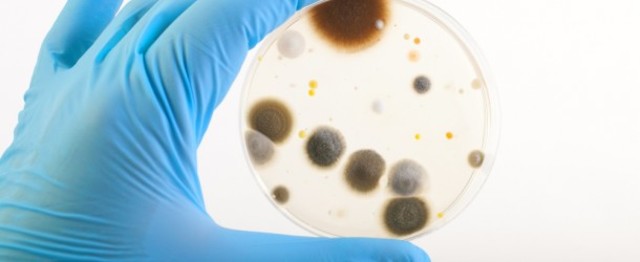
Estudio antimicóticos

-
En civilizaciones griegas, romanas e hindúes se consideraba a los hongos como alimento sagrado.
-
Por el héroe griego Perseo , el tener mucha sed se desencadena el nombre de "mykes" que es una seta que al exprimir calmo su sed.
-
La micología médica surge con la necesidad de tratar enfermedades provocadas en el hombre y en algunos animales a partir del consumo o interacción con los hongos.
-
Es la ciencia que se dedica al estudio de los hongos
-
En la pintura mural de la tumba del faraón Amenemhat, de la XII dinastía.
-
Hasta el siglo XVII los únicos hongos conocidos fueron los macromicetos o setas ,gracias al microscopio de Leeuwenhoek se dio el descubrimiento de hongos microscópicos.
-
Robert Hooke describió los cuerpos fructíferos de los mohos.
-
Agostino Bassi, como micología médica hablo sobre la muscardina del gusano de seda que era producida por un hongo : Beauveria bassiana
-
David Gruby describe la tiña microspórica por Microsporum audouinii, aisló los hongos del favus y el muget.
-
A partir de una serie de enfermedades aumento el interés por el estudio de antimicóticos seguido por el de inmunología sobre todo en diagnósticos.
Plan projects on a visual timeline
Map milestones, phases, deadlines, and key events in one place so the sequence is easier to see and share. Timetoast is a timeline maker for work, school, research, and stories.